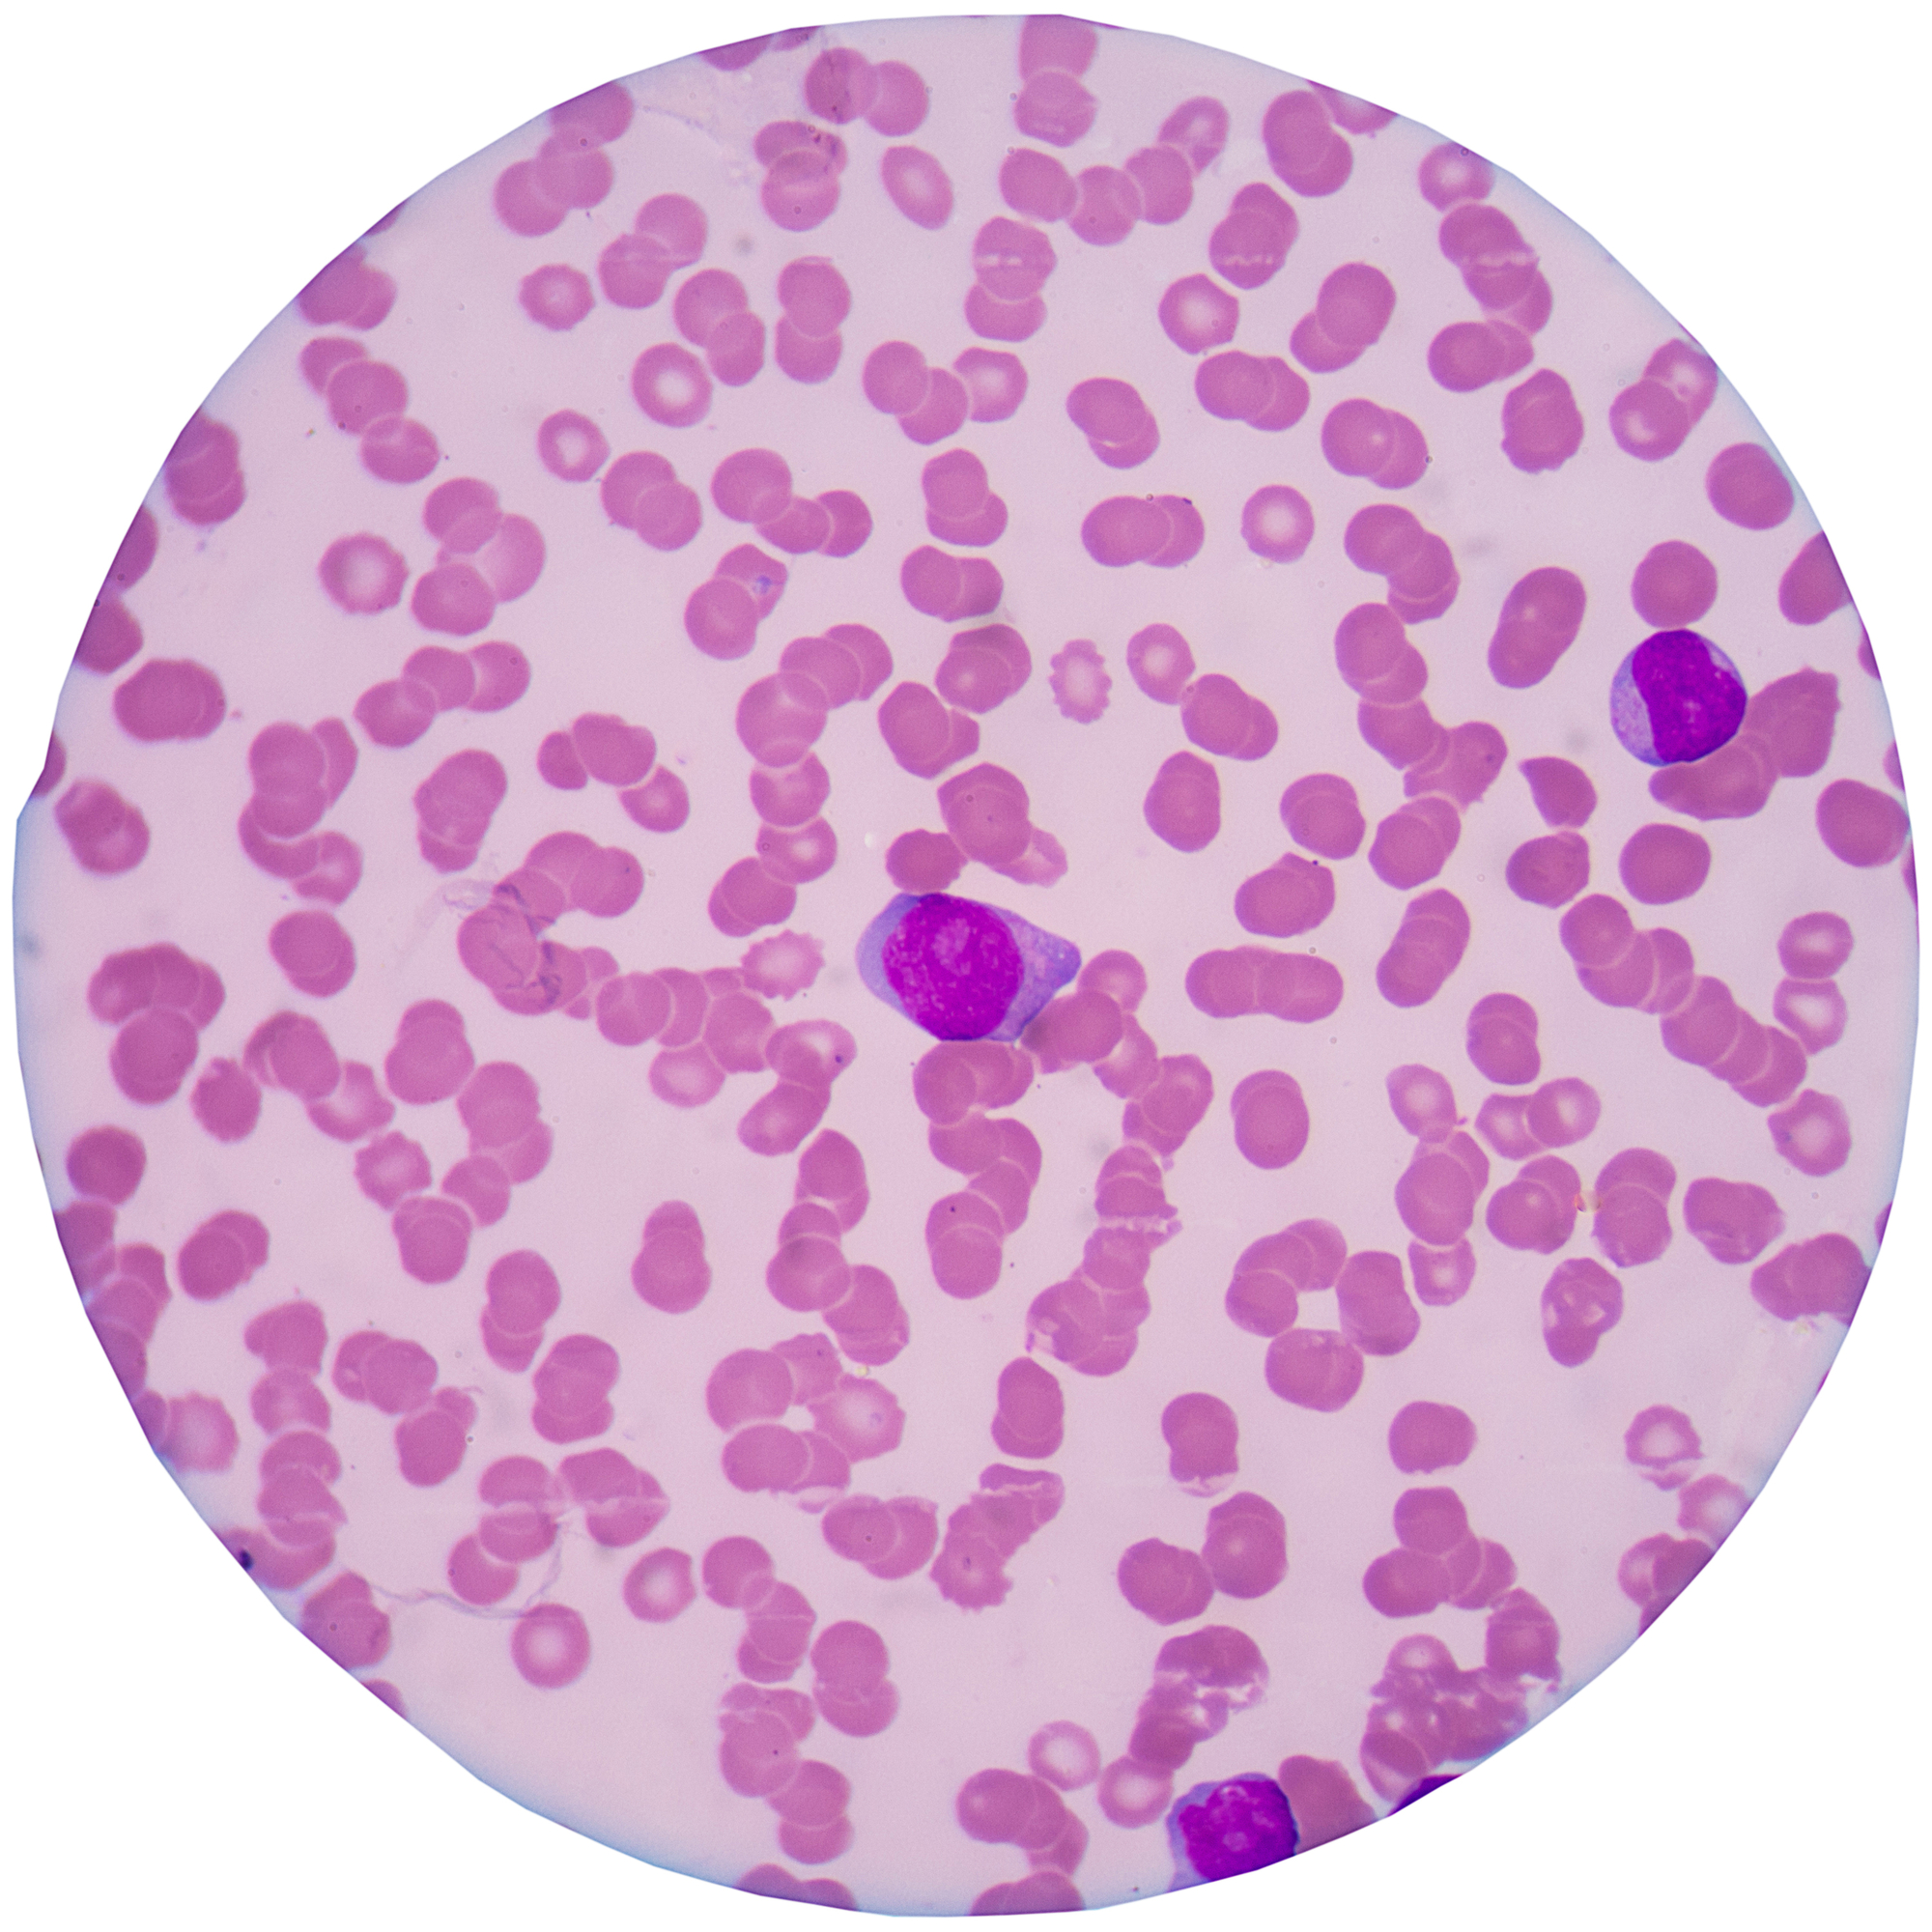

Виберіть своє місто
Для перегляду доступних досліджень та термінів їх виконання

Увійти
Замовити дослідження через кабінет
Замовити дослідження
Служба підтримки
На звʼязку щодня з 07:00 до 20:00
Питання та відповіді
Стати партнером Діла
Відправити pdf на пошту
Заявка на співпрацю
Отримати результати
Про що розповість загальний аналіз крові
02.12.2019Загальний клінічний аналіз венозної крові (ЗАК) відображає загальний стан всієї системи кровотворення. Кількісне і якісне дослідження картини крові дозволяє загалом оцінити основні функції крові, наявність і активність патологічного процесу в організмі. Включає в себе визначення:
- концентрації гемоглобіну;
- величини гематокриту;
- концентрації еритроцитів, тромбоцитів, лейкоцитів;
- лейкоцитарної формули (абсолютної кількості кожного виду лейкоцитів і їх процентного співвідношення до загальної кількості лейкоцитів);
- швидкості осідання еритроцитів;
- розрахунок еритроцитарних і тромбоцитарних індексів.
Як проводиться загальний аналіз крові в ДІЛА |
В медичний лабораторії ДІЛА дослідження «Загальний розгорнутий аналіз крові (автоматичний геманалізатор 33 показника)» проводиться на геманалізаторі Advia 2120i/SIEMENS. В результаті визначаються основні показники крові і йде підрахунок лейкоцитарної формули. У разі, якщо апарат повідомляє про відхилення від референтних значень показників клітин крові (їх кількості, морфологічних змін або порушення співвідношення клітин крові в лейкоцитарній формулі), а також при визначенні атипових клітин крові, відбувається ручний перегляд лікарем-лаборантом лабораторії препарату крові для підтвердження відхилень. Також вручну, в обов'язковому порядку, переглядається препарат крові новонароджених дітей до 30 днів.
Важливо! Основним матеріалом для проведення дослідження є венозна кров. Допускається взяття капілярної крові у дітей віком до трьох років.
Вигляд нормального препарату крові під мікроскопом
За що відповідають показники складу крові |
Лейкоцити
Лейкоцити (білі кров'яні тільця) - клітини крові, які утворюються в кістковому мозку. Основна їхня функція - боротися з інфекцією і пошкодженням тканин організму. Виділяють п'ять основних типів лейкоцитів, які відрізняються за зовнішнім виглядом і виконуваною функцією:
- входять в групу гранулоцитів за рахунок наявності кольорових гранул: еозинофіли, базофіли, нейтрофіли;
- входять в групу агранулоцитів, які не містять кольорових гранул: лімфоцити і моноцити.
 |
 |
| Гранулоцити | Агранулоцити |
Вони присутні в крові у відносно стабільних кількостях і пропорціях, і, хоча їх чисельність може коливатися навіть протягом дня і залежить, в тому числі і від зовнішніх факторів, в нормі, зазвичай, залишаються в межах референтних значень.
Лейкоцити утворюються зі стовбурових клітин кісткового мозку і в процесі дозрівання проходять ряд проміжних стадій, в ході яких і тіло клітини, і її ядро зменшуються. У кровотік же потрапляють лише «зрілі», «дорослі», лейкоцити. Час життя лейкоцитів досить короткий, тому відбувається їх постійне оновлення. Продукція лейкоцитів в кістковому мозку збільшується у відповідь на будь-яке пошкодження тканин, це частина нормальної запальної відповіді. Мета запальної відповіді - відмежування пошкодження, знищення фактора, що його викликав, і відновлення тканини.
Еритроцити (або червоні кров'яні тільця)Еритроцити (або червоні кров'яні тільця) - клітини крові, які не містять ядер, головна функція - транспорт кисню з легенів до тканин і перенесення вуглекислого газу СО2 з тканин в легені. Цей процес здійснюється за допомогою гемоглобіну, який міститься в еритроцитах. Форма у вигляді двояковвігнутого диска являє собою оптимальне співвідношення розміру еритроцита до його поверхні для обміну газами і забезпечує йому здатність деформуватися при проходженні через капіляри. Період життя мають від 90 до 120 днів, потім руйнуються в печінці і селезінці.
|
|
Гемоглобін
Гемоглобін - білок, головна функція якого полягає в транспорті кисню О2 від легенів до тканин і виведення вуглекислого газу СО2 з організму, а також регуляції кислотно-основного стану крові. Завдяки гемоглобіну еритроцит і кров в цілому мають червоний колір.
Гематокрит
Гематокрит - відношення об’єму формених елементів крові (еритроцити, лейкоцити, тромбоцити) до об’єму крові.
 Схематичне зображення тромбоцита |
ТромбоцитиТромбоцити - без'ядерні клітини крові діаметром 2-4 мкм, мають неправильну округлу форму і утворюються в кістковому мозку. Основна функція тромбоцитів - участь у згортанні крові - захисна реакція організму на пошкодження і запобігання втрати крові. При пошкодженні стінки судини пластинки швидко агрегують (склеюються між собою), прилипають до створюваних ниток фібрину, в результаті чого формується тромб, який закриває рану. |
Тромбокрит
Тромбокрит - відношення об’єму тромбоцитів у співвідношенні до загального об’єму крові.
Розрахункові показники, які показують повну картину червоної крові і відображають її здатність до згортання:
- Середній об’єм еритроцитів
- Середній вміст гемоглобіну в одному еритроциті
- Середня концентрація гемоглобіну в еритроцитах
- Ширина розподілу еритроцитів за об'ємом
- Середній об’єм тромбоцитів
- Ширина розподілення тромбоцитів за об'ємом
Лейкоцитарна формула
Лейкоцитарна формула - абсолютна кількість кожного виду лейкоцитів і їх процентне співвідношення до загальної кількості лейкоцитів:
- Загальні нейтрофіли (сума сегментоядерних і паличкоядерних нейтрофілів) - один з видів лейкоцитів з гранулами усередині цитоплазми. Нейтрофіли беруть участь в захисних реакціях організму людини при бактеріальних або інфекційних хворобах за допомогою власних ферментів.
- Сегментоядерні гранулоцити - «зрілі» нейтрофіли, містять сегментоване ядро.
- Паличкоядерні гранулоцити - «молода» форма нейтрофілів, що містить одне ядро.
- Лімфоцити - головні клітинні елементи імунної системи, які утворюються в кістковому мозку і активно функціонують в лімфоїдній тканині. Головна функція лімфоцитів - розпізнавання чужорідного антигену та участь в адекватній імунологічній відповіді організму.
- Моноцити - великі одноядерні лейкоцити, які відносяться до агранулоцитів. Моноцити - найбільші клітини крові. Потрапляючи в тканини, вони перетворюються в макрофаги. Макрофаги - великі клітини, які активно руйнують бактерії. Порівняно з нейтрофілами, моноцити більш активні щодо вірусів, ніж бактерій, і не руйнуються під час реакції з чужорідним антигеном, тому в осередках запалення викликаного вірусами гній не формується. Також моноцити накопичуються в осередках хронічного запалення.
- Еозинофіли - тип лейкоцитів, які отримали свою назву через те, що фарбуються кислим барвником - еозином. Як і нейтрофіли, здатні до фагоцитозу і є мікрофагами, тобто можуть, на відміну від макрофагів, поглинати лише відносно дрібні чужорідні частинки або клітини. Еозинофіли завдяки наявності гістамінази мають здатність поглинати і розщеплювати гістамін, а також ряд інших медіаторів алергії та запалення. Вони також при необхідності можуть вивільняти ці речовини, подібно базофілам. Тобто еозинофіли здатні грати як проалергічну, так і захисну, антиалергічну роль. Вміст еозинофілів в крові збільшується при алергічних станах.
- Базофіли (тучні клітини) - клітини крові, які містять у своїй цитоплазмі грубі лілово-сині гранули, які фарбуються основними барвниками, за що й отримали свою назву. Основний компонент гранул базофілів - гістамін. Тривалість життя - 8-12 діб, період циркуляції у периферичній крові, як і у всіх гранулоцитів, нетривалий - кілька годин. Головна функція базофілів - участь у реакціях гіперчутливості негайного типу. Вони також беруть участь в реакціях гіперчутливості сповільненого типу, в запальних і алергічних реакціях, в регуляції проникності судинної стінки.
- Метамієлоцити і мієлоціти - клітини-попередники клітин крові. Як правило, знаходяться в кістковому мозку, а в крові визначаються лише при наявності запалення або як свідчення лейкозу.
- Віроцити - це своєрідні лімфоцити, що мають деякі морфологічні риси моноцитів. Вони містять одне ядро. Наявність атипових мононуклеарів (віроцитів) - найбільш характерна ознака інфекційного мононуклеозу, хоча вони можуть з'являтися і при інших вірусних захворюваннях.
Швидкість осідання еритроцитів за методом Westergren (ШОЕ)
Швидкість осідання еритроцитів за методом Westergren (ШОЕ) - неспецифічний лабораторний показник, що відображає співвідношення фракцій білків плазми; зміна ШОЕ може служити непрямою ознакою перебігу запального або іншого патологічного процесу, наприклад, анемії або пухлинного росту. Проба ґрунтується на здатності еритроцитів в позбавленій можливості згортання крові осідати під дією гравітації.
Але підкреслюю, що даний показник є вкрай неспецифічним і залежить від багатьох факторів, які впливають на процес осідання еритроцитів, отже, використовувати його можна тільки в сукупності з іншими показниками крові і іншими дослідженнями.
Норми референтних значень за віком і статтю можна знайти в описі дослідження на сайті.
Навіщо потрібен загальний аналіз крові і чому він такий популярний |
Загальний клінічний аналіз крові - рутинне лабораторне дослідження, яке використовується в якості базового, і зазвичай є досить інформативним при наявності видимої чи прихованої клінічної симптоматики (в разі загострення), показники якого часто повертаються до норми при стабілізації стану.
Також загальний аналіз крові може використовуватися і в якості скринінгового дослідження, коли є маркерним і дозволяє диференціювати пацієнтів за критерієм хворий/здоровий при диспансерному або інших періодичних обстеженнях.
Загальний розгорнутий аналіз крові (ЗАК) дозволяє виявити такі проблеми зі здоров'ям за трьома основними клінічними напрямками:
1. Наявність анемій різного походження та їх диференційна діагностика.
Знижений рівень гемоглобіну (менше 130 г/л у чоловіків і 120 г/л у жінок, у вагітних - до 110 г/л) може свідчити про анемічний синдром, який частіше за все виникає на тлі крововтрати різного ступеня тяжкості. У цьому випадку лікар ставить синдромальний діагноз - анемічний синдром. У цього синдрому може бути багато причин, а саме:
- недостатнє засвоєння заліза;
- дефіцит вітаміну В12;
- нестача фолієвої кислоти при різних захворюваннях шлунково-кишкового тракту;
- прийом деяких лікарських препаратів, що пригнічують засвоєння заліза;
- вагітність/лактація;
- на тлі важких інфекційних захворювань;
- може виникнути на тлі важкої фізичної роботи в поєднанні з посиленим потовиділенням.
На що ж потрібно звернути увагу, щоб запідозрити анемію будь-якого походження:
- блідість шкірних покривів і видимих слизових оболонок;
- слабкість;
- підвищена стомлюваність;
- дратівливість;
- шум або дзвін у вухах;
- запаморочення;
- задишка;
- виникнення посиленого серцебиття навіть при незначному фізичному навантаженні;
- алопеція (випадіння волосся);
- зміна форми (ложкоподібність) або посмугованість нігтьових пластинок;
- виникнення заїд в кутах рота;
- запалення язика - глосситу (у вигляді появи нальоту, відчуття печіння в язикові, втрата або зміна смакової чутливості);
- спотворення смаку (хлороз) і запаху;
- іноді - діуретичні зміни.

Для підтвердження та диференційної діагностики анемій, при наявності анемічного синдрому в загальному аналізі крові, раджу пройти Програму 175 "Вияви причину анемії", і звернутися до вашого сімейного лікаря для оцінки, діагностики і подальшого лікування.
2. Ознаки запальних змін у крові
Як правило, запальний процес в організмі поєднується з наявністю підвищеної температури тіла - лихоманки, складного біологічного процесу організму, який полягає в підвищенні температури тіла вище 380С.
Як відрізнити бактеріальну інфекцію від вірусної за загальним розгорнутим аналізом крові:
- У разі наявності бактеріальної інфекції, як правило, спостерігається підвищення кількості лейкоцитів в крові переважно за рахунок збільшення кількості нейтрофілів (нейтрофільоз). Спостерігається так званий зсув лейкоцитарної формули вліво - збільшення кількості і пропорції паличкоядерних нейтрофілів, можуть з'явитися молоді форми, такі як метамієлоцити (юні) і мієлоціти. Як наслідок - можливе відносне (в процентному співвідношенні, а не кількісному) зниження вмісту лімфоцитів - відносна лімфопенія. Також ШОЕ (швидкість осідання еритроцитів) - зазвичай значно підвищується.
Для підтвердження бактеріальної інфекції рекомендую пройти дослідження на С-реактивний білок (СРБ) - кількісний.
- У разі наявності вірусної інфекції, кількість лейкоцитів в крові, як правило, залишається в межах референтних значень (можливо навіть зниження їх кількості - лейкопенія, або помірне збільшення - помірний лейкоцитоз). Зміни в лейкоцитарній формулі відбуваються за рахунок збільшення вмісту лімфоцитів (лімфоцитоз) і/або моноцитів (моноцитоз), відповідно спостерігається відносне зниження кількості нейтрофілів. ШОЕ може незначно підвищуватися, хоча при сильному вірусному навантаженні ШОЕ може мати досить високі показники.
Важливо! Навіть при наявності відхилень, що підтверджують запальні зміни в крові, не починайте прийом антибіотиків без призначення лікаря, це може привести до резистентності збудника до антибіотиків і можливих ускладнень перебігу інфекції.
3. Наявність гематологічних змін крові
Поява «молодих» («юних»), «бластних» форм, недиференційованих клітин, а також зменшення чи абсолютної кількості лейкоцитів, еритроцитів і тромбоцитів. Такі зміни вимагають якнайшвидшого звернення до вашого сімейного лікаря з можливим направленням до лікаря-гематолога для визначення причин, подальшої діагностики і лікування.
Також рекомендується здавати «Загальний розгорнутий аналіз крові (автоматичний геманалізатор 33 показника)» в наступних випадках:
- При скринінговому обстеженні з профілактичною метою, особисто я раджу проходити не рідше одного разу на рік, а краще - два рази на рік і при кожному диспансерному обстеженні.
- Перед кожним візитом до вашого сімейного лікаря та планової госпіталізацією.
- За рекомендацією лікаря - частіше, для контролю медикаментозної терапії, а також радіо- або хіміотерапії.
- Для спортсменів і жінок, які мають рясні менструації, рекомендується проходити дослідження «Загальний розгорнутий аналіз крові (автоматичний геманалізатор 33 показника)» частіше - щоквартально.





 Еритроцити
Еритроцити


